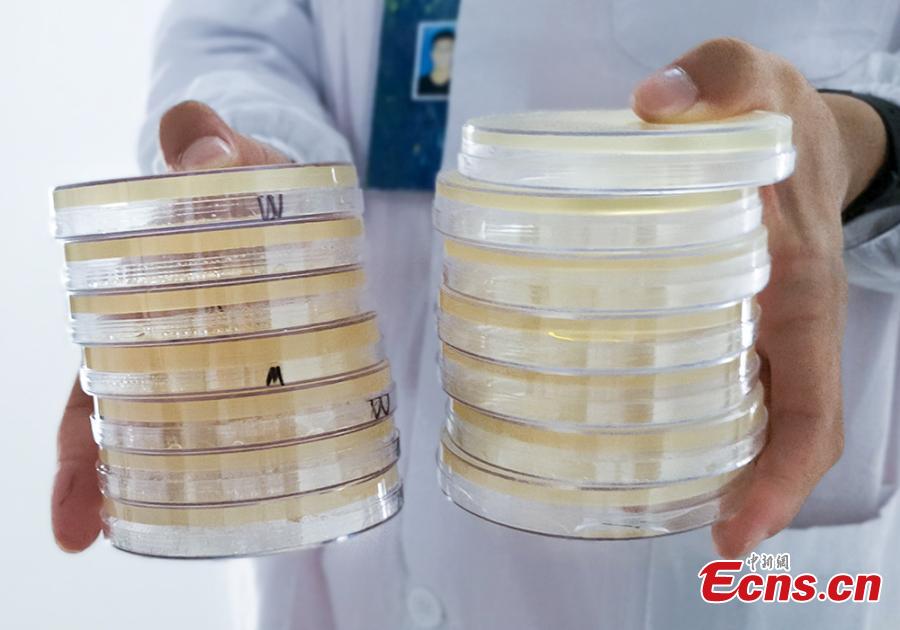

Patterns formed with bacteria are shown in petri dishes during a microbial art competition at China Pharmaceutical University in Nanjing, East China’s Jiangsu province. Students of the school have created artworks by placing various strains of bacteria like staphylococcus and colibacillus into petri dishes, and letting the microbes react and spread across carefully drawn patterns. (Photo: China News Service/ Jiang Chen)
Patterns formed with bacteria are shown in petri dishes during a microbial art competition at China Pharmaceutical University in Nanjing, East China’s Jiangsu province. Students of the school have created artworks by placing various strains of bacteria like staphylococcus and colibacillus into petri dishes, and letting the microbes react and spread across carefully drawn patterns. (Photo: China News Service/ Jiang Chen)

Patterns formed with bacteria are shown in petri dishes during a microbial art competition at China Pharmaceutical University in Nanjing, East China’s Jiangsu province. Students of the school have created artworks by placing various strains of bacteria like staphylococcus and colibacillus into petri dishes, and letting the microbes react and spread across carefully drawn patterns. (Photo: China News Service/ Jiang Chen)

Patterns formed with bacteria are shown in petri dishes during a microbial art competition at China Pharmaceutical University in Nanjing, East China’s Jiangsu province. Students of the school have created artworks by placing various strains of bacteria like staphylococcus and colibacillus into petri dishes, and letting the microbes react and spread across carefully drawn patterns. (Photo: China News Service/ Jiang Chen)




















